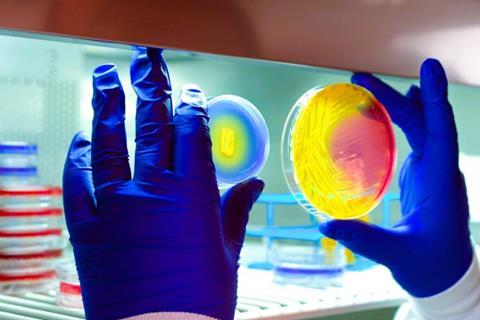
image (4)

Since the 1940s, antibiotics have been our primary weapon against harmful bacterial infections. But some stubborn pathogens, like Staphylococcus aureus, can infect and hide within our own immune cells, making it incredibly difficult for antibiotics to reach and eliminate them.
Brian Conlon, PhD, associate professor of microbiology and immunology at the UNC School of Medicine, and postdoctoral fellow Kuan-Yi Lu, PhD, have thought outside of the box.
Instead of focusing on stronger antibiotics, the researchers explored ways to alter our own immune cells to help antibiotics work more effectively in the body. Conlon and Lu have identified a small molecule that alters the body’s immune cells, forcing them to “wake up” dormant bacteria within and make them more vulnerable to antibiotic treatment.
READ MORE: Diabetes can drive the evolution of antibiotic resistance, study reveals
READ MORE: Scientists reveal role of notorious cell subpopulation in antibiotic failure
As described in a paper in Nature Microbiology, the introduction of the small molecule was effective at helping antibiotics better eliminate the bacteria responsible for staph, tuberculosis, and salmonella infections—three of the most common and serious infections worldwide.
“20,000 people die every year from antibiotic-resistant Staph infections, which means that we need new ways to make antibiotics work better,” said Conlon. “For the first time, we have shown that you can target the host to get better antibiotic outcomes.”
Small molecules
Researchers screened 5,000 small molecules to see which ones were most apt at activating and killing dormant bacteria. In collaboration with UNC’s Small Molecule Screening Core, they exposed each compound to immune cells infected with staph bacteria.

To see which compounds were most effective, researchers used modified luminescent staph bacteria that glow a bright color when activated or “awakened”, much like a heat signature. The brighter the light, the more active the bacteria had become—and the easier it would be for antibiotics to seek out and destroy the hidden invaders.
Stand-out compound
One compound stood out. Researchers then introduced the compound in mouse models which, given in tandem with antibiotics, showed significant improvement in antibiotic performance against Staphylococcus aureus and other bacteria that hide within immune cells, including Mycobacterium tuberculosis, and Salmonella enterica.
“We found that this was a really good approach and an important proof of concept,” said Conlon. “S. aureus died much better when we use this small molecule, and then we found that it also worked against other intracellular pathogens, too.”
Conlon and Lu are now focused on pinpointing exactly how the molecule interacts with immune pathways, patenting the molecule for pharmacological use, and determining whether similar strategies could help enhance treatment for other hard-to-treat bacterial infections.
No comments yet